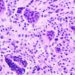

1. Return to baseline function was comparable in tenecteplase and standard-of-care groups.
2. More deaths and intracranial hemorrhages were reported among patients on tenecteplase.
Evidence Rating Level: 1 (Excellent)
Study Rundown: Individuals with minor ischemic stroke and intracranial occlusion have poor prognosis. Intravenous (IV) thrombolysis with tenecteplase may benefit these patients, although little is known. This randomized controlled trial aimed to assess the safety and efficacy of IV tenecteplase in patients with minor ischemic stroke. The primary outcome of this study was return to baseline functioning on the pre-morbid modified Rankin Scale (mRS) score at 90 days, while a key secondary outcome was safety profile. According to study results, tenecteplase did not significantly improve the primary outcome, while also demonstrating a higher mortality rate compared to standard-of-care. Although this study was well done, it was stopped early, which may affect the robustness of the findings.
Click to read the study in The Lancet
Relevant Reading: Tenecteplase for Ischemic Stroke at 4.5 to 24 Hours without Thrombectomy
In-depth [randomized controlled trial]: Between Apr 27, 2015, and Jan 19, 2024, 886 patients were enrolled across 48 hospitals in 10 countries. Included were patients ≥ 18 years of age with minor acute ischemic stroke (defined as National Institutes of Health Stroke Scale [NIHSS] score 0-5) and intracranial occlusion or focal perfusion abnormality, within 12 hours from stroke onset. Altogether, 867 patients (425 in tenecteplase and 442 in standard-of-care) were included in the final analysis. The primary outcome of a return to baseline functioning at 90 days was comparable between groups (72% in tenecteplase vs. 75% in placebo, risk ratio [RR] 0.96, 95% confidence interval [CI] 0.88-1.04, p=0.29). The secondary outcome revealed more deaths in the tenecteplase group than control (5% vs. 1%, adjusted hazard ratio [aHR] 3.8, 95% CI 1.4-10.2, p=0.0085). Overall, findings from this study suggest that IV tenecteplase does not benefit and may cause harm in patients with minor stroke.
Image: PD
©2024 2 Minute Medicine, Inc. All rights reserved. No works may be reproduced without expressed written consent from 2 Minute Medicine, Inc. Inquire about licensing here. No article should be construed as medical advice and is not intended as such by the authors or by 2 Minute Medicine, Inc.